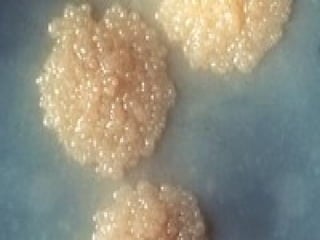

Le document aborde le traitement de la tuberculose, définie comme une maladie infectieuse à transmission respiratoire. Il détaille les objectifs et les moyens du traitement curatif, notamment les différentes classes d'antituberculeux et leur posologie, ainsi que les enjeux liés à la résistance aux médicaments. En outre, il souligne l'importance du traitement préventif et de la surveillance pour contrôler cette maladie endémique.